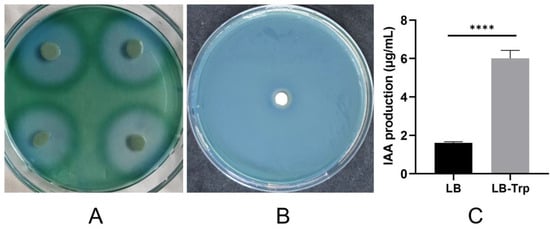

Abstract
Halotolerant plant growth-promoting bacteria (HT-PGPB) have attracted considerable attention for their significant potential in mitigating salt stress in crops. However, the current exploration and development of HT-PGPB remain insufficient to meet the increasing demands of agriculture. In this study, an HT-PGPB isolated from coastal saline-alkali soil in the Yellow River Delta was identified as Glutamicibacter endophyticus J2-5-19. The strain was capable of growing in media with up to 13% NaCl and producing proteases, siderophores, and the plant hormone IAA. Under 4‰ salt stress, inoculation with strain J2-5-19 significantly increased the wheat seed germination rate from 37.5% to 95%, enhanced the dry weight of maize seedlings by 41.92%, and notably improved the development of maize root systems. Moreover, this work presented the first whole-genome of Glutamicibacter endophyticus, revealing that G. endophyticus J2-5-19 resisted salt stress by expelling sodium ions and taking up potassium ions through Na+/H+ antiporters and potassium uptake proteins, while also accumulating compatible solutes such as betaine, proline, and trehalose. Additionally, the genome contained multiple key plant growth-promoting genes, including those involved in IAA biosynthesis, siderophore production, and GABA synthesis. The findings provide a theoretical foundation and microbial resources for the development of specialized microbial inoculants for saline-alkali soils.
1. Introduction
Soil salinization is a major agricultural issue, as salt stress can negatively impact the entire lifecycle of plants, greatly limiting the productivity of arable land. Statistics show that about 1 billion hectares of land globally are affected by salinization [1].
Halophytes are the dominant species in saline-alkali soils, and plant growth-promoting bacteria (PGPB) present in the roots and rhizosphere of halophytes help support their resistance and adaptation to salt stress [2]. Compared to plant growth-promoting bacteria in non-saline soils, those associated with halophytes generally exhibit greater tolerance to high salt concentrations [3]. These bacteria are referred to as Halotolerant plant growth-promoting bacteria (HT-PGPB). HT-PGPBs have significant potential for alleviating salt stress in non-halophyte plants, and in recent years, numerous studies have highlighted their application in mitigating crop salt stress. These strains are distributed across 21 genera, including Bacillus, Pseudomonas, Arthrobacter, Kocuria, Serratia, and others (Table 1).
Glutamicibacter endophyticus was originally isolated from the roots of the halophyte Salsola affinis C. A. Mey in the Urumqi area of Xinjiang, China. It was identified as a new member of the genus Arthrobacter, and was named Arthrobacter endophyticus, with the type strain EGI 6500322T (=DSM 28750=JCM 30091=KCTC 29490) [4]. Busse reviewed the taxonomic studies of the genus Arthrobacter and proposed Glutamicibacter as a new taxonomic unit [5]. He also conducted a re-analysis of the peptidoglycan structure and polar lipid profile of A. endophyticus, which led to its reclassification as Glutamicibacter endophyticus [6].
Existing research has shown that Glutamicibacter endophyticus is a species closely associated with plants. Sadeghi et al. isolated a strain of Glutamicibacter sp. N1A3101, which is closely related to G. endophyticus EGI 6500322T, from soil samples of the roots of Urtica dioica (nettle) in Iran. This strain is capable of producing heat-stable alkaline histamine oxidase [7]. Khan et al. isolated G. endophyticus TKE2, TKR6, and TKR8 from both the roots and rhizosphere soil of the halophyte Arthrocnemum macrostachyum in Karachi, Pakistan. These strains have the ability to secrete various extracellular enzymes [8]. Dong et al. reported an endophytic strain G. endophyticus SYSU 333322 isolated from the halophyte Borszczowia aralocaspica in the Shihezi area of Xinjiang, China, which can enhance the resistance of Arabidopsis thaliana to salt and alkali stress [9].
The salt tolerance and plant growth-promoting effects of this species on crops, as well as its genomic characteristics, have not been reported. We isolated a highly salt-tolerant bacterium, J2-5-19, from the rhizosphere soil of Suaeda salsa, a halophyte, in the Yellow River Delta region. The salt tolerance and plant growth-promoting functions of strain J2-5-19 were investigated, and it was identified as Glutamicibacter endophyticus based on phenotypic traits and 16S rRNA gene phylogenetic analysis. G. endophyticus J2-5-19 exhibits plant growth-promoting abilities, including the secretion of protease, iron siderophores, and indole-3-acetic acid (IAA). Further experiments showed that G. endophyticus J2-5-19 significantly increased the germination rate of wheat seeds and promoted the growth of maize under salt stress. To better understand this strain, we sequenced the complete genome of G. endophyticus J2-5-19 and investigated its salt tolerance and plant growth-promoting mechanisms at the genomic level.

Table 1.
Application of Salt-Tolerant PGPBs in Crops.
Table 1.
Application of Salt-Tolerant PGPBs in Crops.
| Bacterial Species | Source Halophyte | Applied Crops | References |
|---|---|---|---|
| Agrobacierium tumefaciens Klebsiella sp. Ochrobactrum anthropi Pseudomonas stutzeri Pseudomonas sp. | Arthrocnemum indicum | peanut | [10] |
| Arthrobacter woluwensis AK1 Microbacterium oxydans AK2 Arthrobacter aurescens AK3 Bacillus megaterium AK4 Bacillus aryabhattai AK5 | Artemisia princeps Chenopodium ficifolium Oenothera biennis Echinochloa crus-galli | soybean | [11] |
| Bacillus sp. Arthrobacter pascens | Atriplex leucoclada Suaeda fruticosa | maize | [12] |
| Bacillus pumilus HR Zhihengliuella halotolerans SB | Seidlitzia rosmarinus Halostachys belangeriana | wheat | [13] |
| Bacillus pumilus STR2 Halomonas desiderata STR8 Exiguobacterium oxidotolerans STR36 | Poaceae | Mentha arvensis | [14] |
| Bacillus inaquosorum Bacillus thuringiensis Bacillus proteolyticus | Limoniastrum monopetalum Arthrocnemum indicum Holocnemum strobilaceum | quinoa (Chenopodium quinoa) | [15] |
| Enterobacter asburiae A103 | Salix linearistipularis | Medicago sativa | [16] |
| Glutamicibacter halophytocola KLBMP 5180 | Limonium sinense | tomato | [17] |
| Kocuria turfanensis 2M4 | Suaeda fruticosa | peanut | [18] |
| Pseudarthrobacter oxydans B9 Staphylococcus pasteuri B10 | sorghum | tomato | [19] |
| Paraburkholderia sp. GD17 | Glycine soja | rice | [20] |
| Pseudomonas putida CO1 Bacillus paramycoides CO8 | Cocos nucifera | French bean (Phaseolus vulgaris) | [21] |
| Pseudomonas sp. TE7 Providencia rettgeri SE5 Pantoea agglomerans SE19 | Tamarix gallica Suaeda fruticosa | barley tomato | [22] |
| Pseudomonas chloritidismutans 6L11 | Salicornia | wheat | [23] |
| Streptomyces sp. KLBMP5084 | Limonium sinense | tomato | [24] |
| Serratia marcescens Bacillus velezensis Kocuria rhizophila Kosakonia radicincitans | Sesuvium portulacastrum | Vigna mungo | [25] |
| Serratia sp. NTN6 | Puccinellia tenuiflora | maize | [26] |
| Stenotrophomonas maltophilia BJ01 | Cyperus laevigatus | peanut | [27] |
| Variovorax sp. P1R9 | Distichlis spicata | wheat | [28] |
2. Materials and Methods
2.1. Soil Sample Collection and Strain Isolation
Rhizosphere soil samples of Suaeda salsa were collected from an oil drilling site in Dongying City, Shandong Province, China (37°24′21.50″ N, 118°29′46.00″ E). The sampling site is located in the Yellow River Delta, where the soil is classified as coastal saline soil, with a salt composition similar to seawater, predominantly composed of chloride salts (China Soil Database).
The soil enveloping the root systems of Suaeda salsa plants was dug up with a shovel, placed in sterile sealed bags, and transported to the laboratory at low temperature within 8 h. In a laminar flow hood, the bulk soil was gently shaken off to expose the roots, and the rhizosphere soil adhering closely to the roots was collected using a sterile brush. A total of 5 g of rhizosphere soil was inoculated into Sehgal–Gibbons (S-G) liquid medium containing 5% NaCl, which is composed of 7.5 g/L casein acid hydrolysate, 10 g/L yeast extract, 3 g/L trisodium citrate dihydrate, 20 g/L MgSO4·7H2O, 2 g/L KCl, 0.05 g/L FeSO4·7H2O, and 50 g/L NaCl, with a pH of 7.0–7.2. The culture was incubated at 28 °C in a shaking incubator at 180 rpm for 5 days [29]. The resulting suspension was serially diluted to 10−6, and 100 µL aliquots of the 10−4, 10−5, and 10−6 dilutions were plated onto 5% NaCl S-G agar plates. Single colonies were isolated and repeatedly purified to obtain a pure culture. The strain J2-5-19 has been deposited at the China Center for Type Culture Collection (CCTCC) with the accession number CCTCC M 20241774.
The bulk soil was air-dried, and extracts were prepared using deionized water to measure pH (1:2.5, w:v) and electrical conductivity (EC) (1:5, w:v). The soil extracts had a pH of 7.81 and an EC of 23.2 mS/cm, indicating that the sample is from highly salinized soil.
2.2. Strain Identification
2.2.1. Morphological Identification
The strain was cultured on Luria–Bertani (LB) medium, and its colony morphology was recorded. Gram staining was performed using a Gram stain kit (SL7040, Coolaber, Beijing, China) following the manufacturer’s standard protocol, and the stained cells were observed under an optical microscope (BX53, OLYMPUS, Tokyo, Japan). Bacterial cells from overnight cultures in the LB liquid medium were collected by centrifugation. The cell pellet was then resuspended in a 2.5% glutaraldehyde solution and fixed for 3 h. After fixation, the cells were washed with PBS buffer, followed by gradient dehydration using ethanol solutions of 30%, 50%, 70%, 80%, 90%, and 100%. After dehydration, tert-butanol was used to replace ethanol in the samples three times, and the samples were finally freeze-dried to remove the tert-butanol. The cell morphology was observed under a field emission scanning electron microscope (GeminiSEM 300, ZEISS, Oberkochen, Germany) after platinum sputter coating.
2.2.2. Biochemical Identification
The biochemical characteristics of the strain were identified using the API 20NE kit (bioMérieux, Marcy-l’Étoile, France). The MR-VP test and starch hydrolysis test were performed using commercial identification media (Hopebio, Qingdao, China). The hydrogen sulfide test, Tween hydrolysis test, and oxidase test were carried out according to standard bacterial identification manuals [30]. All experiments were performed in triplicate.
2.2.3. 16S rRNA Gene Identification
The 16S rRNA gene was amplified using the primers 27F (5′-AGAGTTTGATCCTGGCTCAG-3′) and 1492R (5′-TACGACTTAACCCCAATCGC-3′) from fresh colony. The PCR reaction volume was 50 μL, consisting of 4 μL of primer mix (2 μL of each primer), 25 μL of 2× PCR reaction mix (containing DNA polymerase, dNTPs, buffer, and other necessary components), and 19 μL of ultrapure water. PCR conditions were as follows: initial denaturation at 95 °C for 3 min, followed by 31 cycles of 30 s at 94 °C, 30 s at 55 °C, and 1 min 30 s at 72 °C, with a final extension at 72 °C for 5 min. The PCR products were sent to Sangon Biotech for Sanger sequencing.
The sequences were initially analyzed using the blastn tool from NCBI. Type strain 16S rRNA gene sequences of the Glutamicibacter genus were obtained from LPSN (https://lpsn.dsmz.de/) (accessed on 18 December 2024) as reference sequences. A phylogenetic tree was constructed using MEGA 7.0 software.
2.3. Functional Characterization and Plant Growth Promotion Experiments
2.3.1. Salt Tolerance Evaluation of Strains
Seed cultures with an OD600 of 1.0 were prepared and inoculated into an LB liquid medium containing NaCl at concentrations ranging from 0 to 15% (inoculum size: 1%). The cultures were incubated at 37 °C and 180 rpm in a shaking incubator. Samples were collected every 6 h to monitor strain growth.
2.3.2. Evaluation of Plant Growth-Promoting Abilities
The protease production ability of the strains was assessed using casein agar containing bromocresol blue (Hopebio, Qingdao, China) as an indicator. The siderophore production ability of the strains was evaluated using CAS plates [31].
Strain J2-5-19 was inoculated into LB medium and LB medium supplemented with 5 mM tryptophan. The cultures were incubated at 28 °C and 180 rpm in a shaking incubator for 48 h. The fermentation broth concentration (OD600) was measured. After centrifugation, the cell-free supernatant was mixed with an equal volume of Salkowski reagent (1 mL of 0.5 M FeCl3 dissolved in 50 mL of 35% perchloric acid). After a 30-min reaction in the dark, the OD530 value was measured. The standard curve was used to calculate the IAA concentration in the cell-free supernatant [32]. The IAA unit yield in the fermentation broth was determined by calculating the ratio of the IAA concentration in the cell-free supernatant to the fermentation broth concentration (OD600).
For IAA standard curve preparation, standard solutions of IAA at concentrations of 0, 5, 10, 20, 50, and 100 μg/mL were prepared using LB as the solvent. An equal volume of Salkowski reagent was added to each standard solution. After a 30-min reaction at 37 °C in the dark, the OD530 was measured. The standard curve was plotted with OD530 on the x-axis and the standard solution concentration on the y-axis: y = 34.838x − 2.2626 (R2 = 0.9962).
2.3.3. Germination Experiment of Wheat Seeds Under Salt Stress
Salt stress conditions simulating coastal saline-alkali soil were created using sea salt (major components: NaCl 92%, Ca2+ 0.32%, Mg2+ 0.22%). Fresh bacterial cells were collected from the LB medium by centrifugation to prepare suspensions at concentrations of 108, 107, and 106 cfu/mL. Wheat seeds (variety: Jimai 22) were soaked in these suspensions, while the control group seeds were treated with an equal volume of sterile water. The germination experiment under salt stress was conducted using quartz sand as the substrate, which was saturated with a 4‰ sea salt solution. The seeds were cultured at 25 °C for 7 days with 16 h of light and 8 h of darkness per day. Every day, a 4‰ sea salt solution was sprayed onto the substrate to maintain its maximum water-holding capacity, ensuring a constant salinity level throughout the cultivation process. Three replicates were set for each treatment.
2.3.4. Corn Pot Experiment Under Salt Stress
The pot experiment was conducted in a greenhouse at Shandong Agricultural University. The test soil was air-dried agricultural soil (with a salt content of 0.46‰), and 2 kg of soil was placed in each pot. After sowing the corn seeds (variety: Zhengdan 958), the plants were allowed to grow until the two-leaf and one-heart stage, with uniformly healthy seedlings selected for the experiment.
The LB culture containing 109 viable bacteria was diluted with 400 mL of 2% sea salt solution, and 400 mL of the resulting suspension was applied to each pot. The control group was treated with an equal volume of sterile LB medium. Eight replicates were used for each treatment.
The aboveground height was measured after 30 days of treatment. The plants were then harvested, and root images were captured using EPSON GT-X980 scanner (EPSON, Suwa, Japan). The root images were analyzed using the WinRHIZO root analysis system (v2017C). Fresh weight was recorded, and after drying the plants in an oven at 105 °C until a constant weight was achieved, dry weight was measured.
2.4. Genome Sequencing and Analysis
2.4.1. Genome Extraction
Bacterial cells in the logarithmic growth phase were collected by centrifugation, and genomic DNA was extracted using the CTAB method.
2.4.2. Genome Sequencing and Assembly
Whole-genome sequencing was conducted at Personalbio (Shanghai, China) using the Illumina NovaSeq XPlus platform (Illumina, San Diego, CA, USA) and the PacBio Sequel II platform (PacBio, Menlo Park, CA, USA). The sequencing data were assembled into contig sequences using Unicycler (v0.5.0) and Flye software (v2.9.1). These contigs were then refined with second-generation sequencing data using Pilon software (v1.18) to obtain the complete genome sequence.
Gene prediction was performed using GeneMarkS software (v4.32). Non-coding RNA genes were predicted using tRNAscan-SE (v1.3.1), Barrnap (v0.9), and the Rfam database (v14.1). The CRISPR-Cas system was identified using CRISPRCasFinder (v4.2.20). Bacteriophages were predicted using PhiSpy (v4.2.21), and genomic islands were identified using IslandViewer 4.
2.4.3. Comparative Genome Analysis
Genome Blast Distance Phylogeny (GBDP) analysis was conducted using the Type (Strain) Genome Server (TYGS) (https://tygs.dsmz.de) (accessed on 18 December 2024). Genomes of type strains of Glutamicibacter species for comparative genomic analysis were obtained from the NCBI GenBank database and the GCM type strains genome database (Table S1). Digital DNA–DNA Hybridization (dDDH) was determined using the Genome-to-Genome Distance Calculator 3.0 [33]. Average Nucleotide Identity (ANI) was calculated using the JspeciesWS online tool (http://jspecies.ribohost.com/jspeciesws) (accessed on 20 September 2024).
2.4.4. Gene Function Annotation
Genes encoding protein sequences were compared against the eggNOG (COG), NCBI NR, and UniProtKB Swiss-Prot databases using DIAMOND blastp (v2.0.11), with an E-value threshold of 1e-6.The best-hit COG identifier was assigned to each corresponding gene and visualized on a genomic circular map using different colors to represent their classifications. Secondary metabolite biosynthetic gene clusters in strain J2-5-19 were predicted using the antiSMASH 7.0 server (https://antismash.secondarymetabolites.org/) (accessed on 11 November 2024). Protein structure prediction was carried out using AlphaFold2 (v2.3.2), and the predicted structure was visualized using PyMOL (open source v3.0.0).
2.5. Statistical Analysis
The Shapiro–Wilk test was used to assess the normality of the data. For comparisons among multiple groups, the Kruskal–Wallis H test was applied to evaluate whether there were significant differences in the distributions across groups. When significant differences were identified, post hoc pairwise comparisons were performed using the Bonferroni correction. For comparisons between two independent groups, an independent samples t-test was used to assess whether there were significant differences between the means of the two groups. All statistical analyses were conducted using IBM SPSS Statistics 26 software, and statistical significance was determined based on the p value. All graphs were created using GraphPad Prism 8 software.
3. Results and Discussion
3.1. Morphological Characteristics of the Strain
Strain J2-5-19 grew well on S-G agar plates containing 5% NaCl as well as on LB agar plates without NaCl. The growth of this strain is not dependent on high salt concentrations, indicating that it is a salt-tolerant bacterium. On LB agar plates, strain J2-5-19 forms creamy, raised colonies (Figure 1A) with a smooth, moist surface. The strain was Gram-staining-positive and did not form spores (Figure 1B). The fresh samples cultured for 12 h exhibited rod-shaped cells with curved ends, measuring 0.5 µm × 0.8–1.6 µm under scanning electron microscopy (Figure 1C).

Figure 1.
(A) Colony morphology of strain J2-5-19 grown on an LB agar plate. (B) Gram-staining of strain J2-5-19 observed at 1000× magnification; scale bar = 10 μm. (C) Cellular morphology of strain J2-5-19 observed by SEM at 25,000× magnification; scale bar = 300 nm.
3.2. 16S rRNA Gene Sequencing
Sequence comparison of 16S rRNA genes revealed that strain J2-5-19 shared the highest sequence similarity (99.57%) to Glutamicibacter endophyticus based on the 16S rRNA gene. A phylogenetic tree was constructed using the 16S rRNA gene sequences of all species within the Glutamicibacter genus as references, employing the neighbor-joining method. Strain J2-5-19 clustered with the type strain Glutamicibacter endophyticus EGI 6500322T in the same clade (Figure 2), with a bootstrap value of 100%. This phylogenetic classification was further confirmed by a tree constructed using the maximum likelihood method (Figure S1). Therefore, the isolate was preliminarily identified as G. endophyticus J2-5-19.

Figure 2.
Neighbor-joining phylogenetic tree based on 16S rRNA gene sequences of strain J2-5-19 and representative Glutamicibacter species. Bootstrap values at each branch node indicate the percentage of support based on 1000 resampling replicates. Strain J2-5-19 clusters with G. endophyticus EGI 6500322T within the same clade. The scale bar represents 0.002 nucleotide substitutions per site.
3.3. Biochemical Characteristics
G. endophyticus J2-5-19 is oxidase-negative, catalase-positive, and does not produce hydrogen sulfide (H2S). It yields negative results for both the methyl red (MR) and Voges-Proskauer (VP) tests. This strain is positive for the hydrolysis of starch and casein, but negative for the hydrolysis of Tween 20, Tween 40, Tween 60, and Tween 80. Additionally, it is negative for nitrate reduction, indole production, glucose fermentation, arginine dihydrolase, and urease activities. The strain is positive for the hydrolysis of aesculin, gelatin, and 4-nitrophenyl-β-D-glucopyranoside (PNPG). In terms of carbohydrate and acid assimilation, it is positive for glucose, arabinose, mannose, N-acetylglucosamine, maltose, gluconate, malic acid, citrate, and phenylacetic acid but negative for mannitol, adipic acid, and capric acid. Compared with the type strain G. endophyticus EGI 6500322, strain J2-5-19 exhibited different results in the hydrolysis of Tween 60, urea, and 4-nitrophenyl-β-D-glucopyranoside, as well as in the mannitol assimilation test (Table 2).

Table 2.
Differential biochemical characteristics of strain J2-5-19 and strain EGI 6500322T. +, positive; −, negative; w, weak positive; ND, not determined.
3.4. Genomic Architecture and Comparative Genomic Analysis
The complete genome of G. endophyticus J2-5-19 is a circular DNA molecule, with a total length of 3,516,616 bp and a GC content of 61.54% (Figure 3). It contains 3208 open reading frames, with an average length of 952.32 bp. The ORF region comprises 86.87% of the genome and has a GC content of 62.38%. A total of 2811 coding genes were annotated in the COG database and classified into 20 COG categories. The largest group, comprising 25.4%, consists of S-class genes with unknown functions. Genes from the following categories contribute over 5% of the total, including transcription (K) at 9.43%, amino acid transport and metabolism (E) at 8.93%, carbohydrate transport and metabolism (G) at 6.87%, inorganic ion transport and metabolism (P) at 6.37%, translation, ribosomal structure, and biogenesis (J) at 5.76%, replication, recombination, and repair (L) at 5.59%, and energy production and conversion (C) at 5.19%.

Figure 3.
Genomic circle map of G. endophyticus J2-5-19. From inside to outside, the first circle represents the scale, the second circle represents GC skew, the third circle represents GC content, the fourth and seventh circles represent the COG to which each coding sequence (CDS) belongs, and the fifth and sixth circles represent the location of CDS, transfer RNA, and ribosomal RNA on the genome.
In the genome, six 5S rRNA genes, five 16S rRNA genes, five 23S rRNA genes, sixty-one tRNA genes, and twenty-eight other ncRNA genes were identified. Additionally, the genome contains two CRISPR-Cas system structures (Table S2), twenty-six genomic islands (Table S3), and twenty-five prophage regions (Table S4) were predicted.
Using TYGS for Genome BLAST Distance Phylogeny (GBDP) analysis, the matched reference strains all belong to the Glutamicibacter genus. G. endophyticus J2-5-19 and Glutamicibacter endophyticus JCM 30091 cluster together on the phylogenetic tree, indicating a very close phylogenetic relationship between the two strains (Figure 4).

Figure 4.
GBDP tree inferred with FastME 2.1.6.1 from GBDP distances calculated from genome sequences. The branch lengths are scaled in terms of GBDP distance formula d5. The numbers above branches are GBDP pseudo-bootstrap support values >60% from 100 replications, with an average branch support of 92.1%.
Considering that the reference genomes are draft sequences, we based our analysis on the digital DNA:DNA hybridization (dDDH) results calculated using Formula 2 (Identities/HSP length). The dDDH result indicates that the DDH estimate between J2-5-19 and Glutamicibacter endophyticus is 67.4% (64.4–70.3%), slightly below 70%. The GC difference between the two strains is only 0.01%. After performing Average Nucleotide Identity (ANI) calculations for species in the Glutamicibacter genus, we found that the ANIb and ANIm values between strain J2-5-19 and Glutamicibacter endophyticus were both above 95%. Based on the above analysis, strain J2-5-19 was identified as Glutamicibacter endophyticus (Table 3).

Table 3.
Results of Average Nucleotide Identity (ANI) calculations, digital DNA–DNA hybridization (dDDH) estimates, and GC content differences between closely related strains.
In addition, we found that the ANIb and ANIm values between Glutamicibacter ardleyensis and Glutamicibacter bergerei were both above 95%, and their DDH estimate was 79.7% (76.8–82.4%). The difference in GC content was 0.24%, indicating that the two strains are actually the same species. According to the principle of priority based on publication date, Glutamicibacter ardleyensis should be regarded as a synonym of Glutamicibacter bergerei [34,35].
3.5. Salt Tolerance and Mechanism of Salt Resistance in the Strain
The salt tolerance experiment demonstrated that G. endophyticus J2-5-19 could grow within a NaCl concentration range of 0–13% (w/v). Over a 72-h cultivation period, the strain exhibited similar growth rates at NaCl concentrations of 0–3%, reaching maximum cell densities at around 40 h. Thereafter, the bacterial growth entered the decline phase (Figure 5). At 72 h, the cell densities in the media containing 5% and 7% NaCl were higher than those in 1% and 0% NaCl, with the strain remaining in a stationary phase. When the NaCl concentration exceeded 3%, bacterial growth was increasingly inhibited, with the degree of inhibition rising alongside the salt concentration. At a NaCl concentration of 13%, bacterial growth was minimal, with OD600 values remaining below 1.

Figure 5.
Growth curves of strain J2-5-19 under different NaCl concentrations. Data points represent the mean of three biological replicates (n = 3), with error bars indicating the standard deviation (SD) of the mean.
In the genome of G. endophyticus J2-5-19, nine genes associated with Na+ efflux were annotated (Table S5). These included three genes encoding single-subunit Na+/H+ antiporters (apnhaP, nhaA, and gerT), and an mrp operon that encodes multiple resistance and pH adaptation (Mrp) cation/proton antiporters [36,37,38].
The Mrp antiporter is a heterooligomeric complex composed of multiple transmembrane proteins. It uses protons as a driving force to expel monovalent cations, thereby conferring bacterial tolerance to high Na+ concentrations or alkaline environments [39]. The mrp operon of G. endophyticus J2-5-19 consists of six genes, encoding an Mrp A subunit with 993 amino acid residues and five smaller subunits (Figure 6). Based on its gene structure, this operon is classified as a Group II mrp operon [40]. This operon is located within a predicted prophage region of the genome (Table S4, pp_22), suggesting that it may have been acquired through horizontal gene transfer.

Figure 6.
(A) Structure of the mrp operon (B) The predicted structure of the Mrp protein complex.
Under salt stress conditions, halotolerant bacteria are able to maintain an osmotic pressure balance between the inside and outside of the cell by accumulating high concentrations of intracellular potassium ions. In the genome of G. endophyticus J2-5-19, eleven genes related to potassium ion uptake were annotated (Table S6). These genes encode potassium uptake proteins such as TrkA, KtrA/B, and KimA, as well as the two-component regulatory system proteins KdpD/KdpE [41,42,43].
The ion regulatory mechanism primarily functions to counteract transient salt shocks, whereas the accumulation of compatible solutes serves as a bacterial strategy to adapt to long-term osmotic stress [44]. Compatible solutes are highly water-soluble organic small molecules that help maintain high intracellular osmotic pressure without adversely affecting normal cellular physiological activities [45]. Several genes associated with the synthesis of compatible solutes were annotated in the genome of G. endophyticus J2-5-19, (Table S7). For example, the codA and gbsA genes are responsible for the conversion of choline to glycine betaine (Figure 7A) [46,47]. The gdh, gltB/D, yerD, and glnA/E genes are involved in the synthesis of glutamate and glutamine, with glutamate further converted into proline by the proB/A/C genes (Figure 7B) [48,49,50].

Figure 7.
The biosynthetic mechanisms of several compatible solutes (A) Biosynthetic pathway of glycine betaine; (B) Biosynthetic pathways of glutamate, glutamine, and proline; (C) Biosynthetic pathway of trehalose; (D) Biosynthetic pathway of inositol; (E) Biosynthetic pathway of sorbitol.
In addition to amino acids and their derivatives, G. endophyticus J2-5-19 can synthesize polyols such as trehalose, sorbitol, and inositol. The treP, TPP1, and otsA genes encode enzymes involved in trehalose biosynthesis (Figure 7C) [51,52,53]. The IMP3 and ino1 genes encode enzymes required for inositol biosynthesis (Figure 7D) [54]. Meanwhile, the SORD gene encodes sorbitol dehydrogenase, which catalyzes the reversible interconversion between fructose and sorbitol (Figure 7E) [55].
Multiple genes involved in the uptake of compatible solutes were identified in the genome of G. endophyticus J2-5-19 (Table S8). The multi-component system comprising opuAA, opuAC, and ousW transports glycine betaine and choline [56,57]; proY, proP, opuE, and putP are responsible for proline uptake [58,59,60]; and gluA/B/C/D and glnM/Q encode proteins involved in the transport of glutamate and glutamine, respectively [61]. The ggtD/C/B genes encode the GgtABCD transport system, which participates in the uptake of glucosylglycerol (GG), sucrose, and trehalose, while the cscB gene encodes a sucrose permease that facilitates sucrose transport into the cell [62,63]. Additionally, proteins encoded by proP and lcoP are also capable of transporting tetrahydropyrimidine [64]. The BRA1188 and tauB genes are likely involved in taurine uptake [65,66].
3.6. Growth-Promoting Ability of the Strain and Genomic Interpretation
G. endophyticus J2-5-19 was capable of forming a blue hydrolysis zone on casein agar plates (Figure 8A), indicating extracellular protease activity. Additionally, it grew on CAS agar plates and formed a yellow halo around the colonies (Figure 8B), demonstrating its ability to secrete siderophores. The IAA production capability of strain J2-5-19 was assessed using the Salkowski colorimetric method. In the LB medium, the IAA yield in the fermentation supernatant was 1.60 ± 0.06 μg/mL. Under supplementation with 5 mM L-Trp, the IAA yield increased to 6.01 ± 0.15 μg/mL, representing a 274% enhancement, which was statistically highly significant (p < 0.0001) (Figure 8C). This finding suggests that the IAA production of G. endophyticus J2-5-19 is tryptophan-dependent.
Figure 8.
(A) Growth of strain J2-5-19 on casein agar plates; (B) Growth of strain J2-5-19 on CAS agar plates; (C) IAA production by strain J2-5-19 in LB medium and LB supplemented with tryptophan (5 mM). Data are presented as mean ± SD (n = 5 for each treatment). Statistical significance was analyzed using independent sample t-tests. Error bars represent the standard deviation (SD) of the mean. Asterisks indicate statistical significance (****, p < 0.0001).
To investigate the growth-promoting effect of G. endophyticus J2-5-19 under salt stress conditions, a wheat germination experiment was conducted using a 4‰ sea salt solution to simulate a coastal saline environment. The germination rate of the control group was 37.5%. In contrast, wheat seeds treated with bacterial suspensions at concentrations of 106, 107, and 108 cfu/mL achieved median germination rates of 90%, 80%, and 95%, respectively. The group treated with 108 cfu/mL showed a significant difference relative to the control group (p < 0.05) (Figure 9A). Additionally, the strain significantly enhanced the growth of seedlings after germination. Over the seven-day cultivation period, coleoptiles and embryonic roots in the control group exhibited slow growth. In comparison, the seeds treated with bacterial suspension developed true leaves from coleoptiles, primary roots from embryonic roots, and secondary roots emerging from primary roots or the basal root region (Figure 9B). These results demonstrated that G. endophyticus J2-5-19 exerted a significant growth-promoting effect during the germination stage.

Figure 9.
(A) Seed germination rates after treatment with different concentrations of bacterial suspensions under salt stress. Data are presented as median with interquartile range (n = 3 for each treatment). Statistical significance was determined using the Kruskal–Wallis H test with Bonferroni correction. An asterisk indicates statistical significance (*, p < 0.05). (B) Wheat seedlings treated with G. endophyticus J2-5-19 show improved growth compared to the control.
A pot experiment was conducted to evaluate the plant growth-promoting effects of G. endophyticus J2-5-19 on maize under 4‰ soil salinity. Maize plants were harvested 30 days after treatment with G. endophyticus J2-5-19, and visual comparisons revealed a significant growth-promoting effect, as shown by the larger plant size and root system (Figure 10A). Compared to the control group, after 30 days of treatment with G. endophyticus J2-5-19 inoculum, plant height increased significantly by 19.63% (p < 0.001), while fresh weight and dry weight increased by 69.46% (p < 0.001) and 41.92% (p < 0.01), respectively. Total root length, root surface area, and root volume increased by 41.49% (p < 0.05), 61.66% (p < 0.01), and 87.02% (p < 0.01), respectively (Figure 10B). These results indicate that J2-5-19 effectively alleviated the adverse effects of salt stress on maize growth. Regarding root development, G. endophyticus J2-5-19 significantly promoted root development in maize seedlings, which enhanced water and nutrient absorption, thereby promoting plant growth.

Figure 10.
(A) Overall plant condition 30 days after treatment (CK: control); (B) Effects of strain J2-5-19 on the agronomic traits of maize. Statistical significance was analyzed using independent sample t-tests. Error bars represent the SD of the mean (n = 8 for each treatment). Asterisks indicate statistical significance (*, p < 0.05; **, p < 0.01; ***, p < 0.001).
Genomic annotation reveals that G. endophyticus J2-5-19 has the capability to degrade soil proteins and mobilize soil iron and phosphorus nutrients. The genome contains six genes encoding extracellular proteases (Table S9), which degrade proteins in the rhizosphere soil, releasing nitrogen sources and providing bioavailable amino acids for both the bacterium and the host plant. Furthermore, the genome includes multiple genes encoding alkaline phosphatases, exopolyphosphatases, and phytases (Table S10). These enzymes enable the strain to degrade organic phosphorus compounds, polyphosphates, and phytates in the soil, converting insoluble phosphates into bioavailable forms, thereby increasing the availability of phosphorus in the soil.
In alkaline soils, free iron is typically scarce. Siderophores can chelate insoluble iron and increase soil bioavailable iron levels. Using antiSMASH, a gene cluster encoding a non-ribosomal peptide synthetase-independent siderophore (NRPS-independent siderophore, NIS) was predicted in the genome. MIBiG comparison showed that this gene cluster shares the highest similarity (similarity score 0.40) with the desferrioxamine E biosynthesis gene cluster in Pantoea agglomerans (Figure 11). Additionally, the genome contains numerous genes related to iron uptake, indicating that G. endophyticus J2-5-19 can competitively acquire various exogenous siderophores, including schizokinen, arthrobactin, enterobactin, petrobactin, and vulnibactin (Table S11). Furthermore, G. endophyticus J2-5-19 can utilize heme-bound iron, ferric citrate, and ferrous iron as iron sources.

Figure 11.
Predicted siderophore biosynthetic gene cluster (BGC) in strain J2-5-19 (upper panel) compared with the desferrioxamine E biosynthetic gene cluster (BGC0001572) from Pantoea agglomerans (lower panel). Lines indicate homologous regions between the two clusters.
The genome of G. endophyticus J2-5-19 contains complete shikimate pathway-encoding genes (Table S12) and tryptophan biosynthesis pathway-encoding genes (Table S13), indicating its ability to autonomously synthesize tryptophan [67]. Additionally, the genome contains genes encoding aromatic amino acid transaminase, tryptophan-2-monooxygenase, a potential indole-3-pyruvate monooxygenase, and several amide oxidases (Table S14). This suggests that the strain may synthesize auxin using tryptophan as a precursor via two pathways. In the indole-3-pyruvate pathway, aromatic amino acid transaminase converts tryptophan into indole-3-pyruvate, which is then oxidatively decarboxylated to indole-3-acetic acid by indole-3-pyruvate flavin monooxygenase [68]. Alternatively, in the indole-3-acetamide pathway, tryptophan-2-monooxygenase oxidatively decarboxylates tryptophan to indole-3-acetamide, which is subsequently hydrolyzed by an amidohydrolase to produce indole-3-acetic acid [69] (Figure 12A).

Figure 12.
(A) IAA biosynthesis pathway involving tryptophan and its intermediates; (B) GABA biosynthesis from L-ornithine through putrescine and related intermediates; (C) Conversion of acetoin to (R,R)-butane-2,3-diol.
In addition, the genome contains a gene encoding cytokinin riboside 5′-monophosphate phosphoribohydrolase (Table S15), which catalyzes the final step of cytokinin biosynthesis [70]. This suggests that G. endophyticus J2-5-19 has the potential to synthesize cytokinins.
G. endophyticus J2-5-19 contains genes associated with the synthesis of beneficial compounds, including γ-aminobutyric acid (GABA), 2,3-butanediol, acetoin, and phenazines. GABA, a key functional amino acid, enhances plant resistance to stress. Genomic analysis suggests that G. endophyticus J2-5-19 synthesizes GABA using putrescine and ornithine as precursors. Genes related to putrescine uptake and ornithine decarboxylation are also present in the genome (Table S16). Putrescine, produced via ornithine decarboxylation or taken up extracellularly, is converted into 4-aminobutyraldehyde by putrescine oxidase (puo) and subsequently oxidized to GABA by gamma-aminobutyraldehyde dehydrogenase (patD) [71,72] (Table S17, Figure 12B).
Volatile organic compounds, including 2,3-butanediol and acetoin, are synthesized and utilized by G. endophyticus J2-5-19 through the acuC and bdhA genes (Table S18). The acuC gene encodes an acetoin utilization protein, while bdhA encodes (R,R)-butanediol dehydrogenase, which catalyzes the reversible conversion between 2,3-butanediol and acetoin [73,74] (Figure 12C).
Additionally, genes encoding PhzF family phenazine biosynthesis proteins (Table S19) were identified in the genome. Phenazine compounds, known for their broad-spectrum antibacterial and antifungal activities, provide a competitive advantage to bacteria in the rhizosphere and protect plants from root pathogens.
4. Conclusions
In this study, a highly salt-tolerant and plant growth-promoting bacterium, G. endophyticus J2-5-19, was isolated and identified from the rhizosphere soil of the halophyte Suaeda salsa in the Yellow River Delta. G. endophyticus J2-5-19 demonstrates high salt tolerance, capable of growing in up to 13% NaCl, with an optimal growth range of 0% to 3%. Meanwhile, strain J2-5-19 had the ability to secrete proteases, siderophores, and indole-3-acetic acid (IAA), and significantly promoted wheat seed germination and maize growth under salt stress. Under 4‰ salt stress, the inoculation of strain J2-5-19 increased wheat germination rate from 37.5% to 95%, and significantly enhanced maize seedling height, root development, and biomass. As the first reported whole-genome of Glutamicibacter endophyticus, the genomic analysis revealed that strain J2-5-19 responded to transient salt stress mainly through ion transporters and adapted to long-term salt stress by synthesizing and transporting compatible solutes. Additionally, the strain harbored multiple key plant growth-promoting genes, such as those involved in IAA biosynthesis, siderophore synthesis, and GABA synthesis. As a novel salt-tolerant plant growth-promoting bacterium, G. endophyticus J2-5-19 contributes to the enrichment of microbial resources and holds significant potential for improving saline-alkaline agricultural ecosystems and increasing crop yields under salt stress conditions.
Supplementary Materials
The following supporting information can be downloaded at: https://www.mdpi.com/article/10.3390/microorganisms13010208/s1.
Author Contributions
L.S.: Investigation, formal analysis, and writing—original draft. S.S.: Conceptualization, writing—review and editing. T.L.: Investigation and resources. X.L.: Investigation and data curation. R.L.: Investigation and validation. J.Z.: Writing—review and editing. S.D.: Software. J.L.: Methodology. Y.D.: Writing—review and editing, funding acquisition, and supervision. All authors have read and agreed to the published version of the manuscript.
Funding
This work was funded by the Joint Funds of the National Natural Science Foundation of China (U23A20143), the Key Research and Development Program of Shandong Province (2023TZXD08602), and the Tai-Shan Scholar Program from the Shandong Provincial Government.
Institutional Review Board Statement
Not applicable.
Informed Consent Statement
Not applicable.
Data Availability Statement
Data are contained within the article or Supplementary Materials. The sequencing data generated in this study have been uploaded to the NCBI database. The GenBank accession number for the 16S rRNA gene is PQ606648, and the genome sequencing and assembly data are available under BioProject PRJNA1187829.
Acknowledgments
We thank Aileen Qu for her support with language revision.
Conflicts of Interest
The authors declare no conflicts of interest.
References
- Singh, A. Soil salinity: A global threat to sustainable development. Soil Use Manag. 2022, 38, 39–67. [Google Scholar] [CrossRef]
- Etesami, H.; Beattie, G.A. Mining Halophytes for Plant Growth-Promoting Halotolerant Bacteria to Enhance the Salinity Tolerance of Non-halophytic Crops. Front. Microbiol. 2018, 9, 148. [Google Scholar] [CrossRef] [PubMed]
- Meena, K.K.; Bitla, U.; Sorty, A.M.; Kumar, S.; Kumar, S.; Wakchaure, G.C.; Singh, D.P.; Stougaard, P.; Suprasanna, P. Understanding the Interaction and Potential of Halophytes and Associated Microbiome for Bio-saline Agriculture. J. Plant Growth Regul. 2023, 42, 6601–6619. [Google Scholar] [CrossRef]
- Wang, H.-F.; Li, L.; Zhang, Y.-G.; Hozzein, W.N.; Zhou, X.-K.; Liu, W.-H.; Duan, Y.-Q.; Li, W.-J. Arthrobacter endophyticus sp. nov., an endophytic actinobacterium isolated from root of Salsola affinis C. A. Mey. Int. J. Syst. Evol. Microbiol. 2015, 65, 2154–2160. [Google Scholar] [CrossRef]
- Busse, H.-J. Review of the taxonomy of the genus Arthrobacter, emendation of the genus Arthrobacter sensu lato, proposal to reclassify selected species of the genus Arthrobacter in the novel genera Glutamicibacter gen. nov., Paeniglutamicibacter gen. nov., Pseudoglutamicibacter gen. nov., Paenarthrobacter gen. nov. and Pseudarthrobacter gen. nov., and emended description of Arthrobacter roseus. Int. J. Syst. Evol. Microbiol. 2016, 66, 9–37. [Google Scholar] [CrossRef] [PubMed]
- Busse, H.-J.; Schumann, P. Reclassification of Arthrobacter endophyticus (Wang et al. 2015) as Glutamicibacter endophyticus comb. nov. Int. J. Syst. Evol. Microbiol. 2019, 69, 1057–1059. [Google Scholar] [CrossRef]
- Sadeghi, H.; Arjmand, S.; Ranaei Siadat, S.O.; Fooladi, J.; Ebrahimipour, G. A novel thermostable alkaline histamine oxidase from Glutamicibacter sp. N1A3101, induced by histamine and its analogue betahistine. AMB Express 2020, 10, 176. [Google Scholar] [CrossRef]
- Khan, T.; Alzahrani, O.M.; Sohail, M.; Hasan, K.A.; Gulzar, S.; Rehman, A.U.; Mahmoud, S.F.; Alswat, A.S.; Abdel-Gawad, S.A. Enzyme Profiling and Identification of Endophytic and Rhizospheric Bacteria Isolated from Arthrocnemum macrostachyum. Microorganisms 2022, 10, 2112. [Google Scholar] [CrossRef] [PubMed]
- Dong, Z.-Y.; Narsing Rao, M.P.; Wang, H.-F.; Fang, B.-Z.; Liu, Y.-H.; Li, L.; Xiao, M.; Li, W.-J. Transcriptomic analysis of two endophytes involved in enhancing salt stress ability of Arabidopsis thaliana. Sci. Total Environ. 2019, 686, 107–117. [Google Scholar] [CrossRef]
- Sharma, S.; Kulkarni, J.; Jha, B. Halotolerant Rhizobacteria Promote Growth and Enhance Salinity Tolerance in Peanut. Front. Microbiol. 2016, 7, 1600. [Google Scholar] [CrossRef] [PubMed]
- Khan, M.A.; Asaf, S.; Khan, A.L.; Adhikari, A.; Jan, R.; Ali, S.; Imran, M.; Kim, K.M.; Lee, I.J. Halotolerant Rhizobacterial Strains Mitigate the Adverse Effects of NaCl Stress in Soybean Seedlings. Biomed. Res. Int. 2019, 2019, 15. [Google Scholar] [CrossRef] [PubMed]
- Ullah, S.; Bano, A. Isolation of plant-growth-promoting rhizobacteria from rhizospheric soil of halophytes and their impact on maize (Zea mays L.) under induced soil salinity. Can. J. Microbiol. 2015, 61, 307–313. [Google Scholar] [CrossRef]
- Amini Hajiabadi, A.; Mosleh Arani, A.; Ghasemi, S.; Rad, M.H.; Etesami, H.; Shabazi Manshadi, S.; Dolati, A. Mining the rhizosphere of halophytic rangeland plants for halotolerant bacteria to improve growth and yield of salinity-stressed wheat. Plant Physiol. Biochem. 2021, 163, 139–153. [Google Scholar] [CrossRef] [PubMed]
- Bharti, N.; Barnawal, D.; Awasthi, A.; Yadav, A.; Kalra, A. Plant growth promoting rhizobacteria alleviate salinity induced negative effects on growth, oil content and physiological status in Mentha arvensis. Acta Physiol. Plant. 2014, 36, 45–60. [Google Scholar] [CrossRef]
- Slatni, T.; Ben Slimene, I.; Harzalli, Z.; Taamalli, W.; Smaoui, A.; Abdelly, C.; Elkahoui, S. Enhancing quinoa (Chenopodium quinoa) growth in saline environments through salt-tolerant rhizobacteria from halophyte biotope. Physiol. Plant. 2024, 176, e14466. [Google Scholar] [CrossRef] [PubMed]
- Li, Y.; Gao, M.; Zhang, W.; Liu, Y.; Wang, S.; Zhang, H.; Li, X.; Yu, S.; Lu, L. Halotolerant Enterobacter asburiae A103 isolated from the halophyte Salix linearistipularis: Genomic analysis and growth-promoting effects on Medicago sativa under alkali stress. Microbiol. Res. 2024, 289, 127909. [Google Scholar] [CrossRef] [PubMed]
- Xiong, Y.-W.; Gong, Y.; Li, X.-W.; Chen, P.; Ju, X.-Y.; Zhang, C.-M.; Yuan, B.; Lv, Z.-P.; Xing, K.; Qin, S. Enhancement of growth and salt tolerance of tomato seedlings by a natural halotolerant actinobacterium Glutamicibacter halophytocola KLBMP 5180 isolated from a coastal halophyte. Plant Soil 2019, 445, 307–322. [Google Scholar] [CrossRef]
- Goswami, D.; Pithwa, S.; Dhandhukia, P.; Thakker, J.N. Delineating Kocuria turfanensis 2M4 as a credible PGPR: A novel IAA-producing bacteria isolated from saline desert. J. Plant Interact. 2014, 9, 566–576. [Google Scholar] [CrossRef]
- Latif, A.; Ahmad, R.; Ahmed, J.; Shah, M.M.; Ahmad, R.; Hassan, A. Novel halotolerant rhizobacterial strains mitigated the salt stress in-vitro and in-vivo and improved the growth of tomato plants. Sci. Hortic. 2023, 319, 112115. [Google Scholar] [CrossRef]
- Zhu, R.; Cao, Y.; Li, G.; Guo, Y.; Ma, L.; Bu, N.; Hao, L. Paraburkholderia sp. GD17 improves rice seedling tolerance to salinity. Plant Soil 2021, 467, 373–389. [Google Scholar] [CrossRef]
- Pandey, S.; Gupta, S. Diversity analysis of ACC deaminase producing bacteria associated with rhizosphere of coconut tree (Cocos nucifera L.) grown in Lakshadweep islands of India and their ability to promote plant growth under saline conditions. J. Biotechnol. 2020, 324, 183–197. [Google Scholar] [CrossRef] [PubMed]
- Bakelli, A.; Amrani, S.; Bouri, M.; Kalayci, S.; Sahin, F. Endophytic bacteria of common tamarisk (Tamarix gallica L.) and alkali seepweed (Suaeda fruticosa (L.) forssk.) as potential biocontrol and plant growth-promoting agents in arid environments. Appl. Ecol. Environ. Res. 2022, 20, 3073–3098. [Google Scholar] [CrossRef]
- Zhou, D.; Yin, Z.; Li, X.; Cui, Y.; Cheng, Q.; Du, B.; Liu, K.; Wang, C.; Ding, Y. Complete Genome Sequence of Pseudomonas chloritidismutans 6L11 with Plant Growth–Promoting and Salt-Tolerant Properties. Mol. Plant-Microbe Interact. 2022, 35, 870–874. [Google Scholar] [CrossRef]
- Gong, Y.; Chen, L.-J.; Pan, S.-Y.; Li, X.-W.; Xu, M.-J.; Zhang, C.-M.; Xing, K.; Qin, S. Antifungal potential evaluation and alleviation of salt stress in tomato seedlings by a halotolerant plant growth-promoting actinomycete Streptomyces sp. KLBMP5084. Rhizosphere 2020, 16, 100262. [Google Scholar] [CrossRef]
- John, J.E.; Maheswari, M.; Kalaiselvi, T.; Prasanthrajan, M.; Poornachandhra, C.; Rakesh, S.S.; Gopalakrishnan, B.; Davamani, V.; Kokiladevi, E.; Ranjith, S. Biomining Sesuvium portulacastrum for halotolerant PGPR and endophytes for promotion of salt tolerance in Vigna mungo L. Front. Microbiol. 2023, 14, 1085787. [Google Scholar] [CrossRef] [PubMed]
- Guo, L.F.; Han, C.; Liu, T.; Wang, Y.M.; Sun, P.; Pang, Q.Y.; Zhang, X.C.; Xiang, W.S.; Zhao, J.W. Integrated physiological, biochemical and transcriptomic analyses reveal the mechanism of salt tolerance induced by a halotolerant Serratia sp. NTN6 in maize. Environ. Exp. Bot. 2024, 221, 16. [Google Scholar] [CrossRef]
- Alexander, A.; Singh, V.K.; Mishra, A.; Jha, B. Plant growth promoting rhizobacterium Stenotrophomonas maltophilia BJ01 augments endurance against N2 starvation by modulating physiology and biochemical activities of Arachis hypogea. PLoS ONE 2019, 14, e0222405. [Google Scholar] [CrossRef]
- Acuña, J.J.; Rilling, J.I.; Inostroza, N.G.; Zhang, Q.; Wick, L.Y.; Sessitsch, A.; Jorquera, M.A. Variovorax sp. strain P1R9 applied individually or as part of bacterial consortia enhances wheat germination under salt stress conditions. Sci. Rep. 2024, 14, 2070. [Google Scholar] [CrossRef] [PubMed]
- Sehgal, S.N.; Gibbons, N.E. Effect of some metal ions on the growth of Halobacterium cutirubrum. Can. J. Microbiol. 1960, 6, 165–169. [Google Scholar] [CrossRef]
- Dong, X.; Cai, M. Manual for Systematic Identification of Common Bacteria; Science Press: Beijing, China, 2001. [Google Scholar]
- Schwyn, B.; Neilands, J.B. Universal chemical assay for the detection and determination of siderophores. Anal. Biochem. 1987, 160, 47–56. [Google Scholar] [CrossRef] [PubMed]
- Gilbert, S.; Xu, J.; Acosta, K.; Poulev, A.; Lebeis, S.; Lam, E. Bacterial Production of Indole Related Compounds Reveals Their Role in Association Between Duckweeds and Endophytes. Front. Chem. 2018, 6, 265. [Google Scholar] [CrossRef]
- Meier-Kolthoff, J.P.; Carbasse, J.S.; Peinado-Olarte, R.L.; Göker, M. TYGS and LPSN: A database tandem for fast and reliable genome-based classification and nomenclature of prokaryotes. Nucleic Acids Res. 2021, 50, D801–D807. [Google Scholar] [CrossRef] [PubMed]
- Chen, M.; Xiao, X.; Wang, P.; Zeng, X.; Wang, F. Arthrobacter ardleyensis sp. nov., isolated from Antarctic lake sediment and deep-sea sediment. Arch. Microbiol. 2005, 183, 301–305. [Google Scholar] [CrossRef] [PubMed]
- Irlinger, F.; Bimet, F.; Delettre, J.; Lefèvre, M.; Grimont, P.A.D. Arthrobacter bergerei sp. nov. and Arthrobacter arilaitensis sp. nov., novel coryneform species isolated from the surfaces of cheeses. Int. J. Syst. Evol. Microbiol. 2005, 55, 457–462. [Google Scholar] [CrossRef] [PubMed]
- Padan, E.; Tzubery, T.; Herz, K.; Kozachkov, L.; Rimon, A.; Galili, L. NhaA of Escherichia coli, as a model of a pH-regulated Na+/H+antiporter. Biochim. Biophys. Acta BBA Bioenerg. 2004, 1658, 2–13. [Google Scholar] [CrossRef] [PubMed]
- Senior, A.; Moir, A. The Bacillus cereus GerN and GerT Protein Homologs Have Distinct Roles in Spore Germination and Outgrowth, Respectively. J. Bacteriol. 2008, 190, 6148–6152. [Google Scholar] [CrossRef]
- Waditee, R.; Hibino, T.; Tanaka, Y.; Nakamura, T.; Incharoensakdi, A.; Takabe, T. Halotolerant Cyanobacterium Aphanothece halophytica Contains an Na+/H+ Antiporter, Homologous to Eukaryotic Ones, with Novel Ion Specificity Affected by C-terminal Tail*. J. Biol. Chem. 2001, 276, 36931–36938. [Google Scholar] [CrossRef]
- Swartz, T.H.; Ikewada, S.; Ishikawa, O.; Ito, M.; Krulwich, T.A. The Mrp system: A giant among monovalent cation/proton antiporters? Extremophiles 2005, 9, 345–354. [Google Scholar] [CrossRef]
- Ito, M.; Morino, M.; Krulwich, T.A. Mrp Antiporters Have Important Roles in Diverse Bacteria and Archaea. Front. Microbiol. 2017, 8, 2325. [Google Scholar] [CrossRef]
- Hamann, A.; Bossemeyer, D.; Bakker, E.P. Physical mapping of the K+ transport trkA gene of Escherichia coli and overproduction of the TrkA protein. J. Bacteriol. 1987, 169, 3138–3145. [Google Scholar] [CrossRef]
- Nakamura, T.; Yuda, R.; Unemoto, T.; Bakker, E.P. KtrAB, a New Type of Bacterial K+-Uptake System from Vibrio alginolyticus. J. Bacteriol. 1998, 180, 3491–3494. [Google Scholar] [CrossRef] [PubMed]
- Gundlach, J.; Herzberg, C.; Kaever, V.; Gunka, K.; Hoffmann, T.; Weiß, M.; Gibhardt, J.; Thürmer, A.; Hertel, D.; Daniel, R.; et al. Control of potassium homeostasis is an essential function of the second messenger cyclic di-AMP in Bacillus subtilis. Sci. Signal. 2017, 10, eaal3011. [Google Scholar] [CrossRef]
- Dinnbier, U.; Limpinsel, E.; Schmid, R.; Bakker, E.P. Transient accumulation of potassium glutamate and its replacement by trehalose during adaptation of growing cells of Escherichia coli K-12 to elevated sodium chloride concentrations. Arch. Microbiol. 1988, 150, 348–357. [Google Scholar] [CrossRef] [PubMed]
- Gunde-Cimerman, N.; Plemenitaš, A.; Oren, A. Strategies of adaptation of microorganisms of the three domains of life to high salt concentrations. FEMS Microbiol. Rev. 2018, 42, 353–375. [Google Scholar] [CrossRef] [PubMed]
- Rand, T.; Halkier, T.; Hansen, O.C. Structural Characterization and Mapping of the Covalently Linked FAD Cofactor in Choline Oxidase from Arthrobacter globiformis. Biochemistry 2003, 42, 7188–7194. [Google Scholar] [CrossRef] [PubMed]
- Zou, H.; Chen, N.; Shi, M.; Xian, M.; Song, Y.; Liu, J. The metabolism and biotechnological application of betaine in microorganism. Appl. Microbiol. Biotechnol. 2016, 100, 3865–3876. [Google Scholar] [CrossRef] [PubMed]
- Saum, S.H.; Sydow, J.F.; Palm, P.; Pfeiffer, F.; Oesterhelt, D.; Müller, V. Biochemical and Molecular Characterization of the Biosynthesis of Glutamine and Glutamate, Two Major Compatible Solutes in the Moderately Halophilic Bacterium Halobacillus halophilus. J. Bacteriol. 2006, 188, 6808–6815. [Google Scholar] [CrossRef] [PubMed]
- Rexer, H.U.; Schäberle, T.; Wohlleben, W.; Engels, A. Investigation of the functional properties and regulation of three glutamine synthetase-like genes in Streptomyces coelicolor A3(2). Arch. Microbiol. 2006, 186, 447–458. [Google Scholar] [CrossRef]
- Csonka, L.N.; Leisinger, T. Biosynthesis of Proline. EcoSal Plus 2007, 2. [Google Scholar] [CrossRef] [PubMed]
- Avonce, N.; Mendoza-Vargas, A.; Morett, E.; Iturriaga, G. Insights on the evolution of trehalose biosynthesis. BMC Evol. Biol. 2006, 6, 109. [Google Scholar] [CrossRef]
- Habibur Rahman Pramanik, M.; Imai, R. Functional Identification of a Trehalose 6-phosphate Phosphatase Gene that is Involved in Transient Induction of Trehalose Biosynthesis during Chilling Stress in Rice. Plant Mol. Biol. 2005, 58, 751–762. [Google Scholar] [CrossRef] [PubMed]
- Koliwer-Brandl, H.; Syson, K.; van de Weerd, R.; Chandra, G.; Appelmelk, B.; Alber, M.; Ioerger, T.R.; Jacobs, W.R., Jr.; Geurtsen, J.; Bornemann, S.; et al. Metabolic Network for the Biosynthesis of Intra- and Extracellular α-Glucans Required for Virulence of Mycobacterium tuberculosis. PLoS Pathog. 2016, 12, e1005768. [Google Scholar] [CrossRef] [PubMed]
- Morita, Y.S.; Fukuda, T.; Sena, C.B.C.; Yamaryo-Botte, Y.; McConville, M.J.; Kinoshita, T. Inositol lipid metabolism in mycobacteria: Biosynthesis and regulatory mechanisms. Biochim. Biophys. Acta (BBA)–Gen. Subj. 2011, 1810, 630–641. [Google Scholar] [CrossRef] [PubMed]
- Karacaoğlan, V.; Özer, I. Steady-state kinetic properties of sorbitol dehydrogenase from chicken liver. Comp. Biochem. Physiol. Part B Biochem. Mol. Biol. 2005, 140, 309–312. [Google Scholar] [CrossRef] [PubMed]
- Choquet, G.; Jehan, N.; Pissavin, C.; Blanco, C.; Jebbar, M. OusB, a Broad-Specificity ABC-Type Transporter from Erwinia chrysanthemi, Mediates Uptake of Glycine Betaine and Choline with a High Affinity. Appl. Environ. Microbiol. 2005, 71, 3389–3398. [Google Scholar] [CrossRef]
- Kempf, B.; Bremer, E. OpuA, an Osmotically Regulated Binding Protein-dependent Transport System for the Osmoprotectant Glycine Betaine in Bacillus subtilis(*). J. Biol. Chem. 1995, 270, 16701–16713. [Google Scholar] [CrossRef] [PubMed]
- Liao, M.-K.; Gort, S.; Maloy, S. A cryptic proline permease in Salmonella typhimurium. Microbiology 1997, 143, 2903–2911. [Google Scholar] [CrossRef][Green Version]
- Peter, H.; Weil, B.; Burkovski, A.; Krämer, R.; Morbach, S. Corynebacterium glutamicum Is Equipped with Four Secondary Carriers for Compatible Solutes: Identification, Sequencing, and Characterization of the Proline/Ectoine Uptake System, ProP, and the Ectoine/Proline/Glycine Betaine Carrier, EctP. J. Bacteriol. 1998, 180, 6005–6012. [Google Scholar] [CrossRef] [PubMed]
- Moses, S.; Sinner, T.; Zaprasis, A.; Stöveken, N.; Hoffmann, T.; Belitsky, B.R.; Sonenshein, A.L.; Bremer, E. Proline Utilization by Bacillus subtilis: Uptake and Catabolism. J. Bacteriol. 2012, 194, 745–758. [Google Scholar] [CrossRef]
- Kronemeyer, W.; Peekhaus, N.; Krämer, R.; Sahm, H.; Eggeling, L. Structure of the gluABCD cluster encoding the glutamate uptake system of Corynebacterium glutamicum. J. Bacteriol. 1995, 177, 1152–1158. [Google Scholar] [CrossRef] [PubMed][Green Version]
- Mikkat, S.; Hagemann, M. Molecular analysis of the ggtBCD gene cluster of Synechocystis sp. strain PCC6803 encoding subunits of an ABC transporter for osmoprotective compounds. Arch. Microbiol. 2000, 174, 273–282. [Google Scholar] [CrossRef] [PubMed]
- Sahintoth, M.; Frillingos, S.; Lengeler, J.W.; Kaback, H.R. Active Transport by the CscB Permease in Escherichia coli K-12. Biochem. Biophys. Res. Commun. 1995, 208, 1116–1123. [Google Scholar] [CrossRef] [PubMed]
- Steger, R.; Weinand, M.; Krämer, R.; Morbach, S. LcoP, an osmoregulated betaine/ectoine uptake system from Corynebacterium glutamicum. FEBS Lett. 2004, 573, 155–160. [Google Scholar] [CrossRef][Green Version]
- Paulsen, I.T.; Seshadri, R.; Nelson, K.E.; Eisen, J.A.; Heidelberg, J.F.; Read, T.D.; Dodson, R.J.; Umayam, L.; Brinkac, L.M.; Beanan, M.J.; et al. The Brucella suis genome reveals fundamental similarities between animal and plant pathogens and symbionts. Proc. Natl. Acad. Sci. USA 2002, 99, 13148–13153. [Google Scholar] [CrossRef] [PubMed]
- Young, J.P.W.; Crossman, L.C.; Johnston, A.W.B.; Thomson, N.R.; Ghazoui, Z.F.; Hull, K.H.; Wexler, M.; Curson, A.R.J.; Todd, J.D.; Poole, P.S.; et al. The genome of Rhizobium leguminosarum has recognizable core and accessory components. Genome Biol. 2006, 7, R34. [Google Scholar] [CrossRef] [PubMed]
- Shende, V.V.; Bauman, K.D.; Moore, B.S. The shikimate pathway: Gateway to metabolic diversity. Nat. Prod. Rep. 2024, 41, 604–648. [Google Scholar] [CrossRef] [PubMed]
- Tivendale, N.D.; Davies, N.W.; Molesworth, P.P.; Davidson, S.E.; Smith, J.A.; Lowe, E.K.; Reid, J.B.; Ross, J.J. Reassessing the Role of N-Hydroxytryptamine in Auxin Biosynthesis. Plant Physiol. 2010, 154, 1957–1965. [Google Scholar] [CrossRef] [PubMed]
- Duca, D.; Lorv, J.; Patten, C.L.; Rose, D.; Glick, B.R. Indole-3-acetic acid in plant–microbe interactions. Antonie Van Leeuwenhoek 2014, 106, 85–125. [Google Scholar] [CrossRef] [PubMed]
- Seo, H.; Kim, K.-J. Structural insight into molecular mechanism of cytokinin activating protein from Pseudomonas aeruginosa PAO1. Environ. Microbiol. 2018, 20, 3214–3223. [Google Scholar] [CrossRef] [PubMed]
- Kurihara, S.; Tsuboi, Y.; Oda, S.; Kim, H.G.; Kumagai, H.; Suzuki, H. The Putrescine Importer PuuP of Escherichia coli K-12. J. Bacteriol. 2009, 191, 2776–2782. [Google Scholar] [CrossRef] [PubMed]
- Ishizuka, H.; Horinouchi, S.; Beppu, T. Putrescine Oxidase of Micrococcus Rubens: Primary Structure and Escherichia coli. Microbiology 1993, 139, 425–432. [Google Scholar] [CrossRef][Green Version]
- Nicholson, W.L. The Bacillus subtilis ydjL (bdhA) Gene Encodes Acetoin Reductase/2,3-Butanediol Dehydrogenase. Appl. Environ. Microbiol. 2008, 74, 6832–6838. [Google Scholar] [CrossRef] [PubMed]
- Grundy, F.J.; Waters, D.A.; Takova, T.Y.; Henkin, T.M. Identification of genes involved in utilization of acetate and acetoin in Bacillus subtilis. Mol. Microbiol. 1993, 10, 259–271. [Google Scholar] [CrossRef] [PubMed]
Disclaimer/Publisher’s Note: The statements, opinions and data contained in all publications are solely those of the individual author(s) and contributor(s) and not of MDPI and/or the editor(s). MDPI and/or the editor(s) disclaim responsibility for any injury to people or property resulting from any ideas, methods, instructions or products referred to in the content. |
© 2025 by the authors. Licensee MDPI, Basel, Switzerland. This article is an open access article distributed under the terms and conditions of the Creative Commons Attribution (CC BY) license (https://creativecommons.org/licenses/by/4.0/).